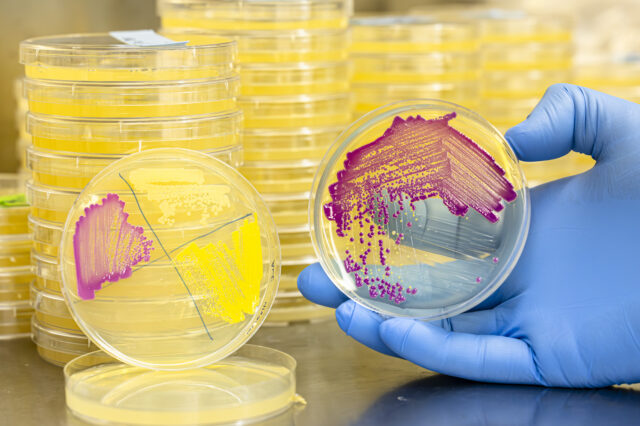
A person wearing blue gloves is holding a petri dish with colorful bacterial cultures. There are stacks of similar petri dishes in the background.

Scientists working with the Center for Bioenergy Innovation (CBI) at the Department of Energy’s Oak Ridge National Laboratory and partner institutions described critical advances and opportunities in synthetic biology for the success of the U.S.-based bioeconomy in a new paper in Biotechnology Advances.
Researchers outlined the feedstocks and molecules needed for biomanufacturing, described the organisms and phenotypic traits needed for performance-advantaged organisms and biomass feedstocks, and identified challenges and opportunities in microbial and plant synthetic biology.
The paper also explored current and future technologies such as artificial intelligence, machine learning and automation that will enable bioeconomy success.
Biology is already good at breaking down and converting materials. Building on that foundation, synthetic biologists are creating a blueprint for tomorrow’s biomanufacturing, using sources such as biomass feedstocks or waste streams to create ultra-efficient factories where every step is optimized, and byproducts are turned into additional profit centers.
“We’ve made great strides in developing new tools to be able to engineer living organisms much more efficiently than in the past, including difficult microbes that are used to thriving in stressful environments,” said Carrie Eckert, a lead author of the paper and co-chief science officer at CBI.
“With our growing capabilities in AI and automation, we’re able to evaluate and transform organisms much faster, accelerating discoveries that will translate biological innovation into industrial-scale impact.”
– Carrie Eckert
Synthetic biologists working with CBI have developed a growing lexicon of tools and processes to rewire microbial and plant processes. From microbes that tolerate industrial conditions to break down and convert materials, to plants that are optimized for deconstruction and conversion, researchers are creating modern assembly lines for the domestic manufacturing of specialty fuels, chemicals and materials at scale.
Advances in DNA sequencing and synthesis, machine learning, automation and cell-free biochemistry — using enzymes as miniature chemical factories — are dramatically accelerating discovery. These tools allow researchers to predict which genes to modify, rapidly prototype new pathways outside living cells and scale promising designs into robust industrial processes. Together, they form the foundation of biofactories that are smarter, faster and adaptable.
In addition to Eckert, ORNL co-authors include Adam Guss, Andrea Garza Elizondo, Ilenne del Valle Kessra, Erica Texeira Prates, Elise Phillips, Nandhini Ashok, Dan Jacobson, Erin Webb, William G. Alexander, Joanna Tannous, Xiaohan Yang and Jerry Tuskan. Co-authors from CBI partners include Evan Komp, Yannick Bomble, Chung-Jui Tsai, Wayne Parrott, Breeanna Urbanowicz, Laura Bartley and Costas Maranas. UT-Battelle manages ORNL for the Department of Energy’s Office of Science, the single largest supporter of basic research in the physical sciences in the United States. The Office of Science is working to address some of the most pressing challenges of our time. For more information, please visit energy.gov/science.
